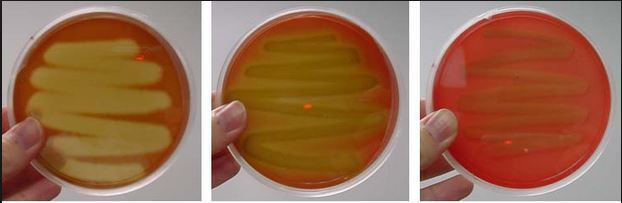
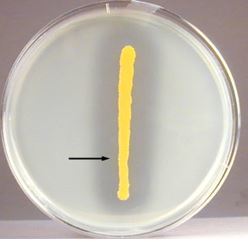
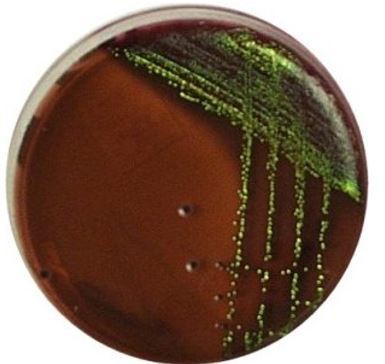
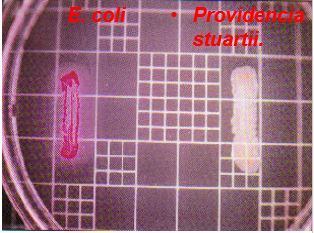

Lysogeny Agar: use, differential, selective
all-purpose; not selective; not differential
MacConkey Agar w/crystal violet: use, differential, selective
isolation and differentiation of Enterobacteriaceae; selective for enteric (salt), and G- (crystal violet); differential for lactose fermentation (turns hot pink)
MSA (Mannitol Salt Agar): use, selective, differential
isolation and differentiation of salt tolerent organisms; selective for salt tolerent G- (7.5% sodium chloride); differential for fermentation of mannitol (yellow)
DNase Agar: use, selective, differential
test for DNase; not selective w/o indicator dyes; differential for DNA hydrolysis (clearing around streak after HCl added)
EMB (Eosin Methylene Blue Agar): use, selective, differential
Isolate fecal coliforms; selective for G- (m. blue); diff. for lactose fermentation: rapid-metallic green, slow-pink
Blood Agar: use, selective, differentiation
differentiation of fastidious organisms associated with animals; not selective; diff for hemolysis: alpha-partial lysis with hemoglobin intact (dark/greenish) beta-complete lysis (transparent) gamma-nonhemolytic (unchanged color)
Lowenstein-Jensen (LJ): use, selective, differential
culture mycobacterium (acid-fast); selective for mycobacterium (malachite green); not differential
What medium is this? What does it test? What are the results?
Blood agar; hemolysis; beta alpha gamma
What medium is this? What does it test for?
DNase Agar; tests for DNase (clearing around streak is evidence of DNA hydrolysis
What is this? What does it test for? What result is this?
Eosin Methylene Blue Agar (EMB); fecal coliforms; green is rapid fermentation of lactose
What is this, what does it test for, what result is this?
MacConkey Agar; enterobacteriaceae; hot pink is fermentation of lactose
What is this, what does it test for, what is the result?

Mannitol Salt Agar (MSA); salt tolerent organisms; yellow is fermentation of mannitol
What is this, what does it test for, what is this result?

Lowenstein-Jensen; mycobacterium; growth of mycobacterium (crumbly dry appearance)


